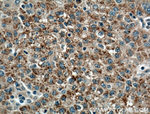
PANK1/2/3 Antibody in Immunohistochemistry (Paraffin) (IHC (P))
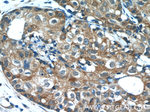
PANK1/2/3 Antibody in Immunohistochemistry (Paraffin) (IHC (P))

Search
Proteintech
PANK1/2/3 Polyclonal Antibody
{{$productOrderCtrl.translations['antibody.pdp.commerceCard.promotion.promotions']}}
{{$productOrderCtrl.translations['antibody.pdp.commerceCard.promotion.viewpromo']}}
{{$productOrderCtrl.translations['antibody.pdp.commerceCard.promotion.promocode']}}: {{promo.promoCode}} {{promo.promoTitle}} {{promo.promoDescription}}. {{$productOrderCtrl.translations['antibody.pdp.commerceCard.promotion.learnmore']}}
产品信息
12466-1-AP
种属反应
宿主/亚型
分类
类型
抗原
偶联物
形式
浓度
规格
纯化类型
保存液
内含物
保存条件
运输条件
产品详细信息
Immunogen sequence: TGIRDVHLE LKDLTLFGRR GNLHFIRFPT QDLPTFIQMG RDKNFSTLQT VLCATGGGAY KFEKDFRTIG NLHLHKLDEL DCLVKGLLYI DSVSFNGQAE CYYFANASEP ERCQKMPFNL DDPYPLLVVN IGSGVSILAV HSKDNYKRVT GTSLGGGTFL GLCSLLTGCE SFEEALEMAS KGDSTQADKL VRDIYGGDYE RFGLPGWAVA SSFGNMIYKE KRESVSKEDL ARATLVTITN NIGSVARMCA VNEKINRVVF VGNFLRVNTL SMKLLAYALD YWSKGQLKAL FLEHEGYFGA VGALLGLPNF S (61-370 aa encoded by BC013705)
靶标信息
This gene encodes a protein belonging to the pantothenate kinase family. Pantothenate kinase is a key regulatory enzyme in the biosynthesis of coenzyme A (CoA) in bacteria and mammalian cells. It catalyzes the first committed step in the universal biosynthetic pathway leading to CoA and is itself subject to regulation through feedback inhibition by CoA. This family member is expressed most abundantly in the liver.
仅用于科研。不用于诊断过程。未经明确授权不得转售。
生物信息学
蛋白别名: Hallervorden-Spatz syndrome; hPanK; hPanK2; hPanK3; mPank; mPanK3; PanK1alpha; PanK1beta; PanK1gamma; PANK2; PanK; UG0370f05; Pantothenate kinase 1; pantothenate kinase 2 (Hallervorden-Spatz syndrome); Pantothenate kinase 2, mitochondrial; Pantothenate kinase 3; pantothenate kinase-associated neurodegeneration; Pantothenic acid kinase 1; Pantothenic acid kinase 2; Pantothenic acid kinase 3; unnamed protein product
基因别名: 4933409I19Rik; AI642621; C20orf48; HARP; HSS; NBIA1; PANK; PANK1; Pank1b; PANK2; PANK3; PKAN
UniProt ID: (Human) Q8TE04, (Human) Q9BZ23, (Human) Q9H999, (Mouse) Q8K4K6, (Mouse) Q7M753, (Mouse) Q8R2W9
Entrez Gene ID: (Human) 53354, (Human) 80025, (Human) 79646, (Mouse) 75735, (Rat) 294088, (Rat) 296167, (Mouse) 74450, (Mouse) 211347, (Rat) 360511